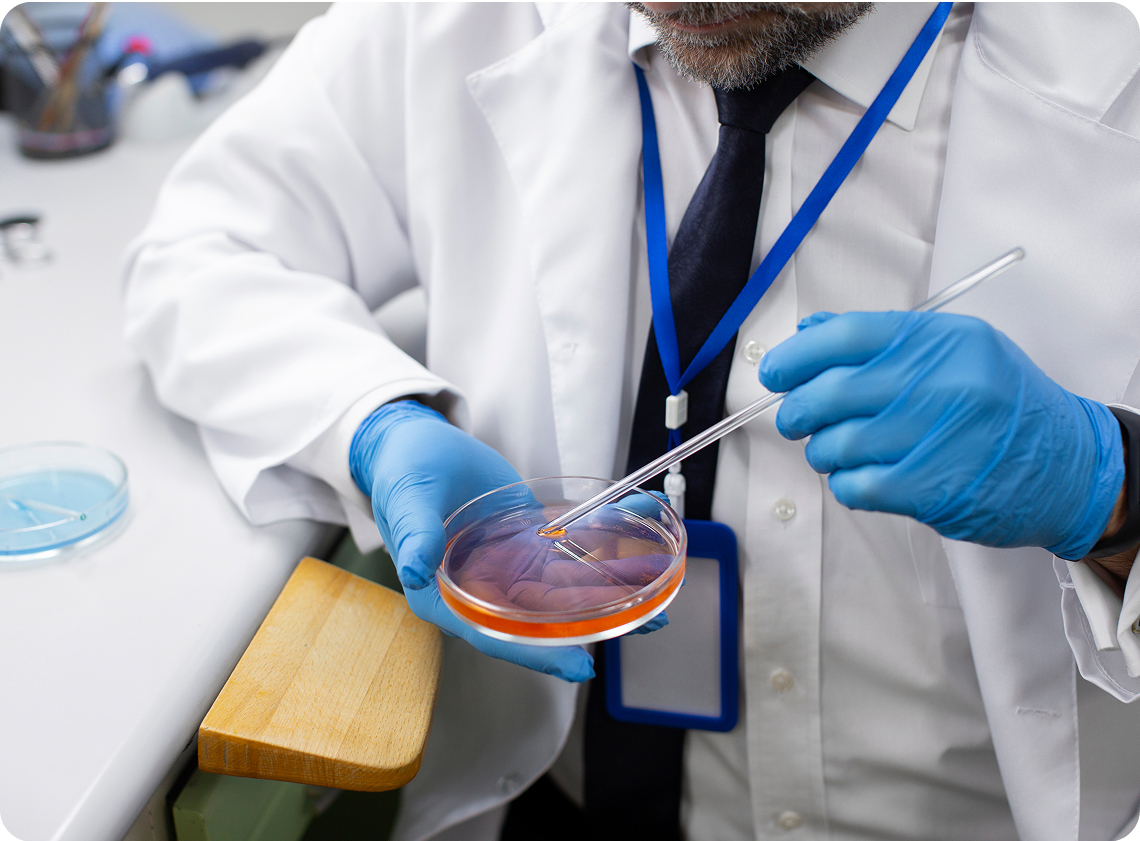

Kalsiyum Aktivasyonu
Tüp bebek tedavisinde döllenme şansını artırmak amacıyla uygulanan en gelişmiş laboratuvar tekniklerinden biri ICSI’dir.
Özellikle sperm sayısı az olan veya sperm hareketliliği düşüklüğü gibi durumların görüldüğü çiftler için, bu yöntem standart IVF’e göre daha yüksek başarı sağlayabilir. Mikroenjeksiyon işlemi olarak da bilinir.


Kalsiyum Aktivasyonu Nedir?
Kalsiyum aktivasyonu, yumurtanın döllenme için hazır hale gelmesini sağlayan hücre içi kalsiyum salınımını laboratuvar ortamında tetikleme işlemidir. Normalde bu süreci tetikleyen etken, spermde bulunan fosfolipaz C zeta adlı bir enzimdir.
Ancak bu enzimin eksikliği veya etkisizliği durumunda, yapay oosit aktivasyonu (AOA) uygulanabilir. AOA, kimyasal (ör. kalsiyum iyonoforu), elektriksel veya mekanik uyarılarla gerçekleştirilir.
Kalsiyum Aktivasyonu Hangi Durumlarda Uygulanır?
Kalsiyum Aktivasyonu, özellikle şu durumlarda tercih edilir:
- Önceki ICSI denemelerinde döllenme oranı çok düşükse.
- Total fertilizasyon başarısızlığı yaşanmışsa.
- Şiddetli erkek faktörlü infertilite varsa.
- Spermde fosfolipaz C zeta aktivitesinin eksik olduğu düşünülüyorsa.
Kalsiyum Aktivasyonu Klinik Açıdan Neden Önemlidir?
Yumurta aktivasyonu olmadan döllenme gerçekleşemez. Kalsiyum iyonoforları gibi kimyasal maddelerle yapılan AOA işlemi, döllenmenin sağlanamadığı vakalarda umut verici bir destek sağlar.
Ancak bu yöntem, tüm vakalar için uygun değildir ve uygulanmadan önce dikkatli bir değerlendirme gerektirir. Ayrıca AOA uygulamalarında standartlar laboratuvarlar arasında farklılık gösterebilir.
Sorabileceğiniz bazı sorular:
- AOA işlemi sonrası döllenme oranlarında iyileşme gözlemlendi mi?
- Uygulamanın embriyo gelişimine etkisi nedir?
- Önceki döngülerde döllenme başarısızlığı olduysa, AOA uygulamayı düşünüyor musunuz?
- Kalsiyum aktivasyonu için hangi yöntemi kullanıyorsunuz (iyonofor, elektriksel, mekanik)?
Bu konuda danışmak ister misiniz?
Sizin durumunuza özel olarak hangi sperm hazırlama yönteminin uygulanabileceğini anlamak ve kliniğinize hangi soruları sormanız gerektiğini netleştirmek için bizimle iletişime geçin.



